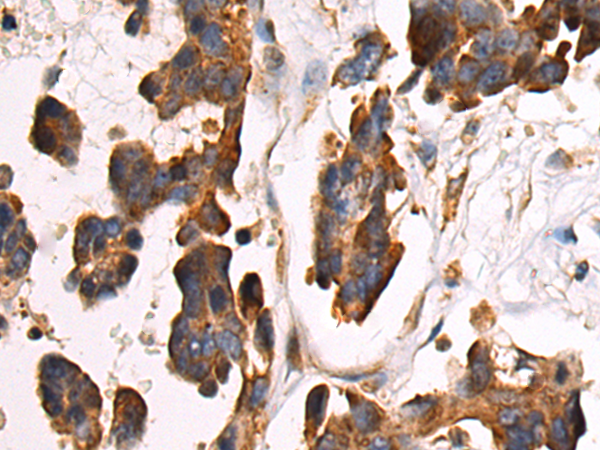

-
分类: 科研抗体货号: P13720别名: ABH5; OFOXD; OFOXD1应用: WB反应种属: Human, Mouse, Rat
-
分类: 科研抗体货号: P13692别名:应用: IHC反应种属: Human, Mouse
-
分类: 科研抗体货号: P13709别名: S3-12; KIAA1881应用: IHC反应种属: Human
-
分类: 科研抗体货号: P13719别名: APR; KPA; LRP; A2MR; CD91; APOER; LRP1A; TGFBR5; IGFBP3R; IGFBP-3R; IGFBP3R1应用: WB,IHC反应种属: Human, Mouse
-
分类: 科研抗体货号: P13707别名: NEZHA; PPP1R80; KIAA1543应用: IHC反应种属: Human, Mouse
-
分类: 科研抗体货号: P13717别名: BCK; B-CK; CKBB; CPK-B; HEL-211; HEL-S-29应用: WB反应种属: Human, Mouse, Rat
-
分类: 科研抗体货号: P13737别名: NKHC; ALS25; MY050; NEIMY; SPG10; D12S1889应用: IHC反应种属: Human, Mouse, Rat
-
分类: 科研抗体货号: P13716别名:应用: IHC反应种属: Human, Mouse
-
分类: 科研抗体货号: P13736别名: URP1; KIND1; DTGCU2; UNC112A; C20orf42应用: IHC反应种属: Human, Mouse
-
分类: 科研抗体货号: P13715别名: RBM35A; RMB35A; DFNB109应用: IHC反应种属: Human, Mouse, Rat

鄂公网安备42018502007531号
鄂公网安备42018502007531号

